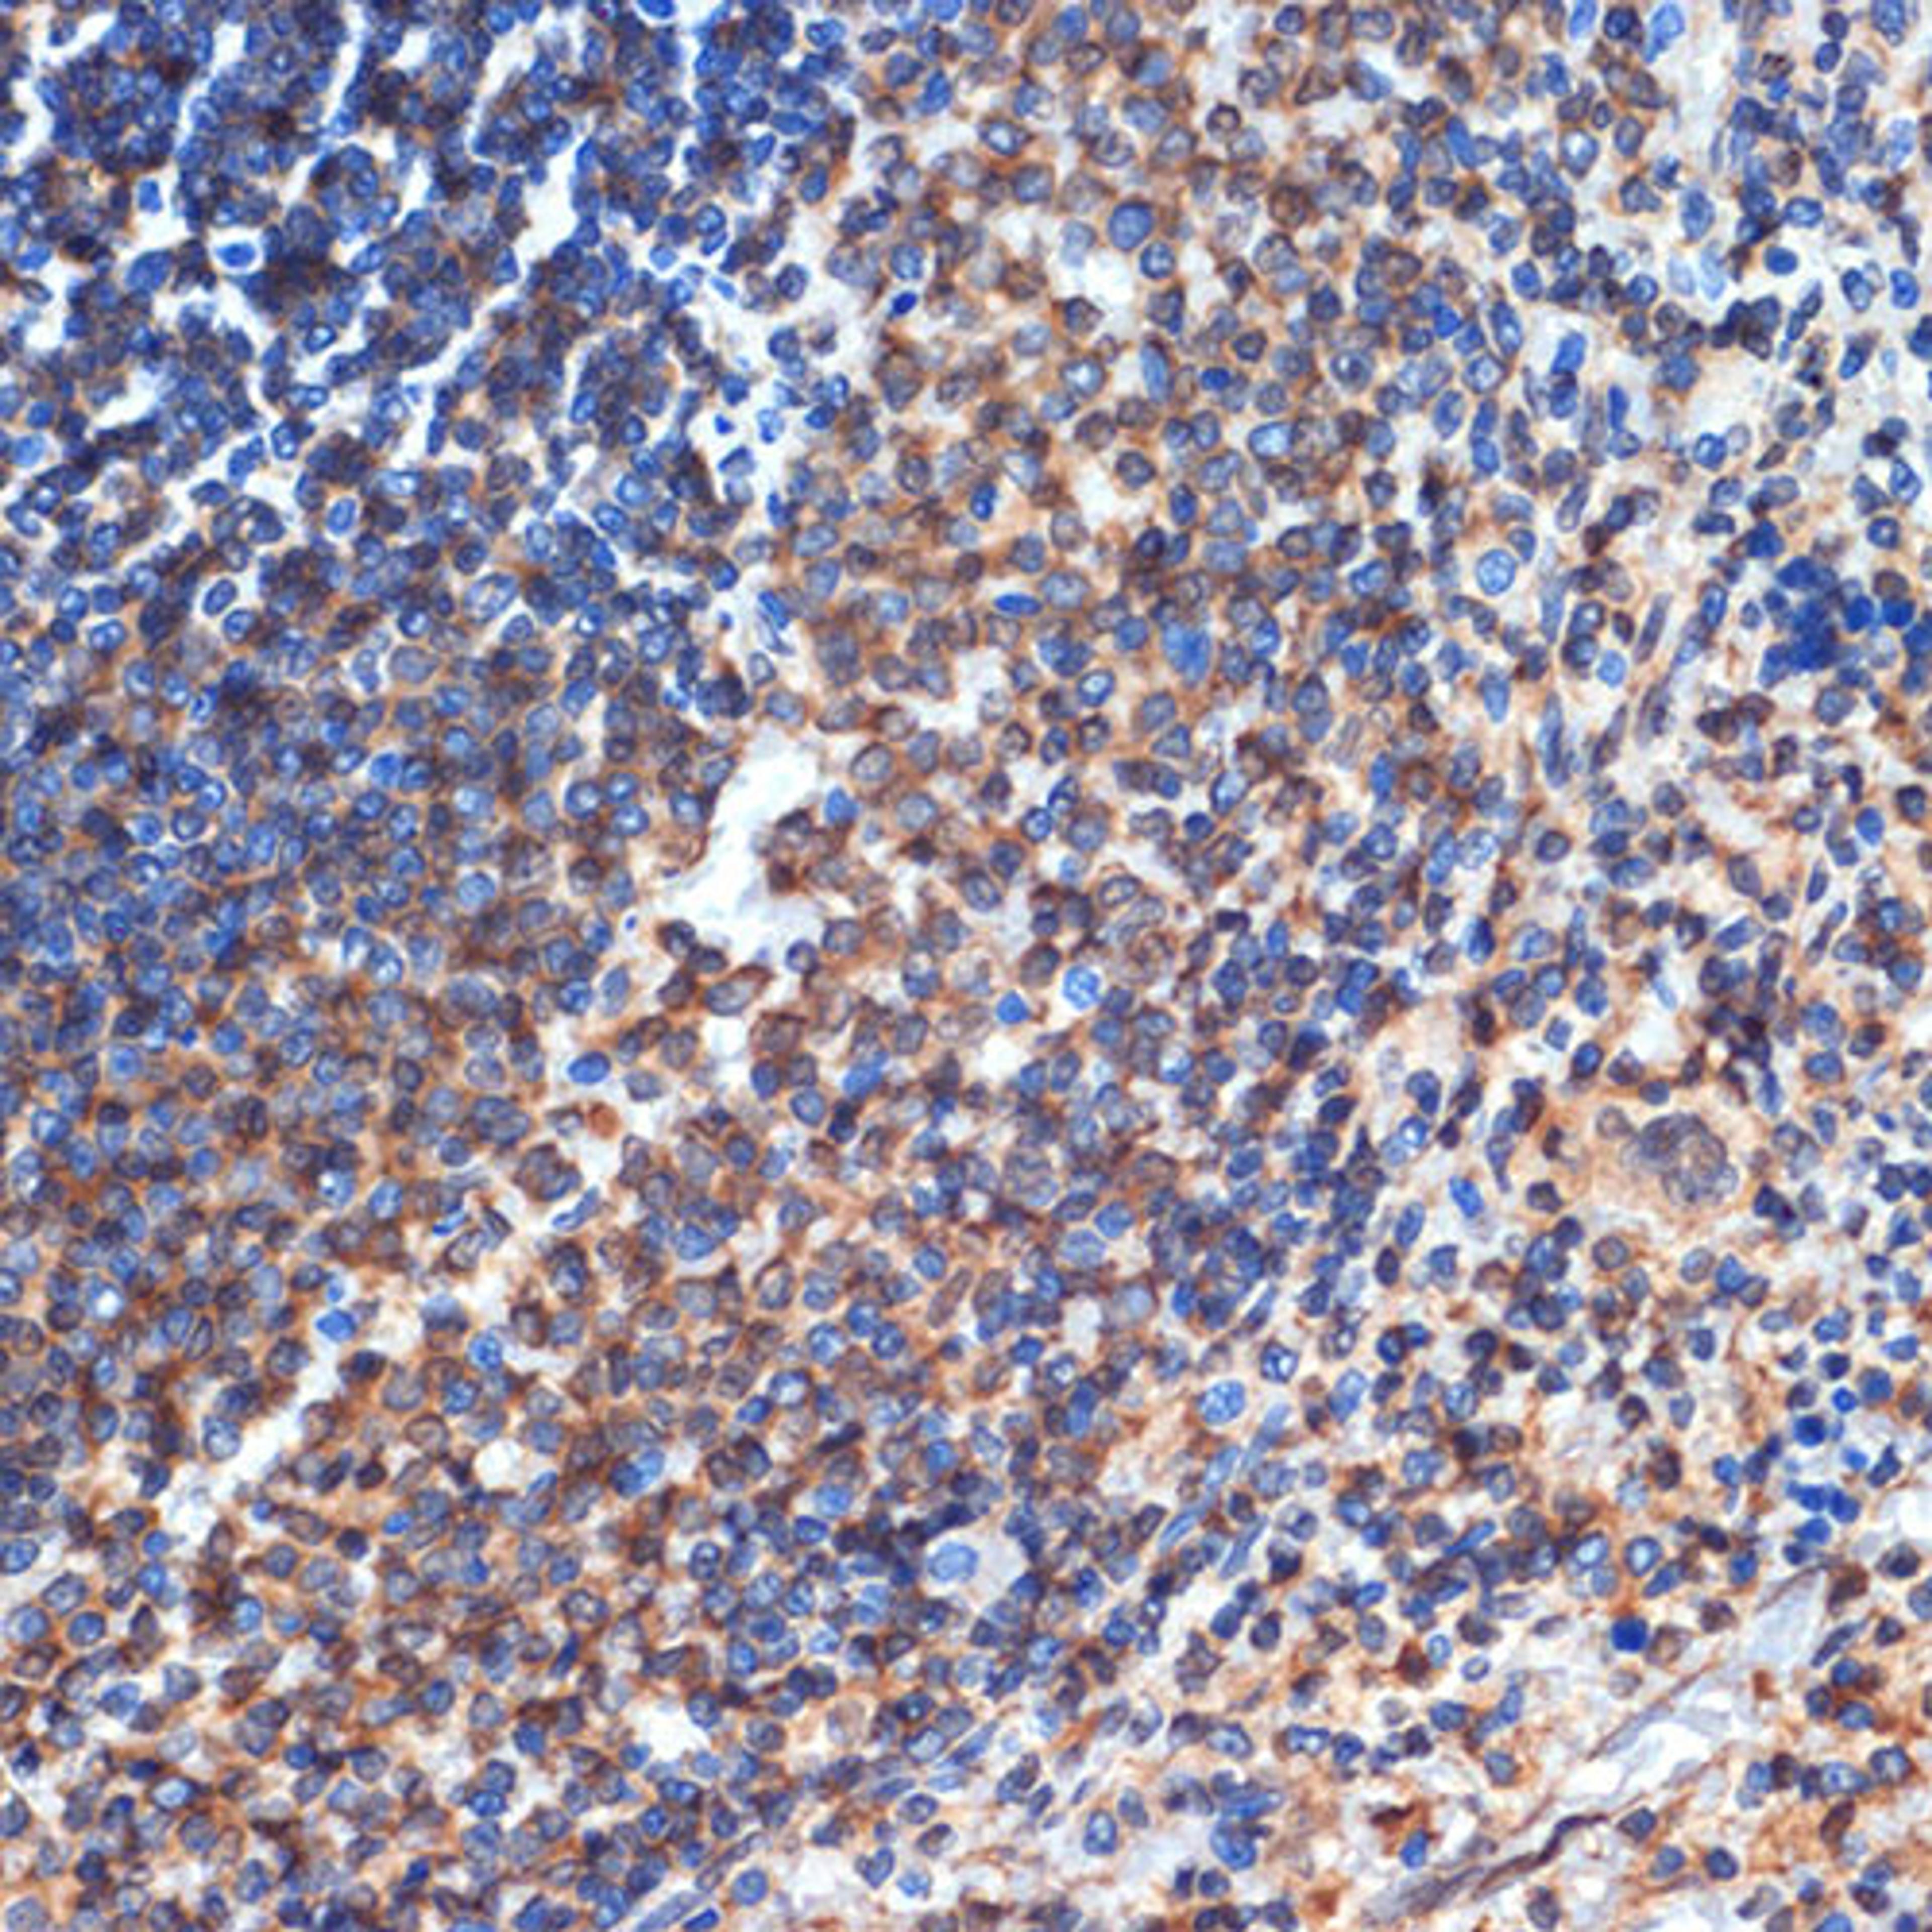
Immunohistochemistry - CD35 Rabbit mAb (A3661)

CD35 Rabbit mAb
Product Details
- Cat. No.
- A3661
- Type
- Primary Antibody
- Clonality
- Monoclonal
- Host
- Rabbit

The supplier does not provide quotations for this antibody through SelectScience. You can search for similar antibodies in our Antibody Directory.
Description
This gene is a member of the receptors of complement activation (RCA) family and is located in the 'cluster RCA' region of chromosome 1. The gene encodes a monomeric single-pass type I membrane glycoprotein found on erythrocytes, leukocytes, glomerular podocytes, and splenic follicular dendritic cells. The Knops blood group system is a system of antigens located on this protein. The protein mediates cellular binding to particles and immune complexes that have activated complement. Decreases in expression of this protein and/or mutations in its gene have been associated with gallbladder carcinomas, mesangiocapillary glomerulonephritis, systemic lupus erythematosus and sarcoidosis. Mutations in this gene have also been associated with a reduction in Plasmodium falciparum rosetting, conferring protection against severe malaria. Alternate allele-specific splice variants, encoding different isoforms, have been characterized. Additional allele specific isoforms, including a secreted form, have been described but have not been fully characterized. [provided by RefSeq, Jul 2008]
Biological Information
- Clonality: Monoclonal
- Host: Rabbit
- Reactivity: Human, Mouse, Rat